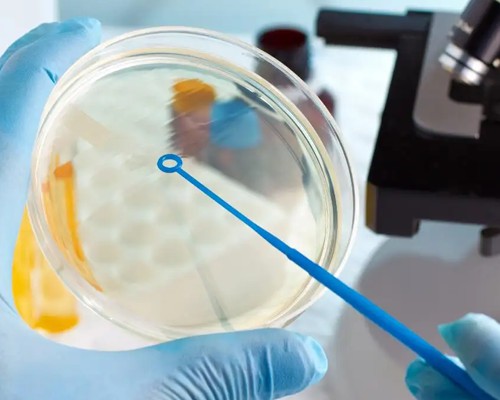

- 卵巢早衰供卵试管多少钱?2026最新费用明细(含卵源费+试管周期成本)
0评论2025-11-20

- 卵巢早衰供卵试管有哪些潜在风险?医生不会主动说的注意事项
0评论2025-11-20

- 卵巢早衰患者的供卵来源有哪些?公立医院vs私立机构的卵源差异对比
0评论2025-11-20

- 卵巢早衰为何需要供卵试管?一文讲清适应症与技术原理
0评论2025-11-20

- 卵巢早衰≠生育终结!供卵试管如何成为最后希望?专家解读关键点
0评论2025-11-20

- 卵巢早衰供卵试管成功率有多高?这些因素直接影响结果
0评论2025-11-20

- 在武汉做供卵试管,这些支持绿通的医院值得了解!
0评论2025-11-20

- 武汉供卵试管绿通申请指南:需要准备哪些材料与条件?
0评论2025-11-20

- 武汉供卵试管绿通服务全解析:快速助孕的绿色通道是什么?
0评论2025-11-20

- 哪些人适合选择武汉供卵试管绿通?精准匹配你的助孕需求
0评论2025-11-20

- 武汉供卵试管绿通适合哪些不孕不育人群?快速匹配解决方案
0评论2025-11-20
胃造瘘护理指导
2.执行灌食之步骤分述如下:(1)将灌食器接上胃管,反抽看看是否有残留食物液体,并将之再打回管子中,此可了解您对前次灌入食物的消化吸收情形,如残留食物液体很多时,表示消化不好,需稍微延长时间再灌食。7.放置胃造瘘管后一星期内或伤口有红、肿、热、痛、潮湿情形,请以消炎药膏涂擦,管子周围应用无菌纱布盖好,再以透气纸胶固定。再以棉棒沾优碘药水以环形方式由内向外消毒皮肤再以生理食盐水擦掉优碘痕迹可以适量消炎药膏涂擦伤口再覆盖上切开布和无切纱布并以纸胶固定。术后,经X光摄影后确定无气体于腹腔内并且无疼痛情形即可于6
0评论2025-11-2036
患癌几率与职业相关
职业性皮肤癌症常发生于接触砷矿、砷杀虫剂和化工的工人。结果发现,人们患癌症的几率和种类与其从事的职业有很大关系,其中餐饮行业的男性服务员罹患癌症的几率最高,最易患的癌症是肺癌、喉癌、口腔癌、舌癌、肝癌、膀胱癌和直肠癌7种癌症。职业性癌症最常发生在皮肤、膀胱和肺,这是因为这些部位易接触致癌物而被吸收。在北欧五国进行的一项最新研究结果显示,人们患癌症的几率与其从事的职业有很大关联。职业性膀胱癌症常发生在生产染料和颜料的工人。而农民则是患癌症几率最低的群体,其次是园艺师、牧师、伐木工人和医生。
0评论2025-11-2038
如何预防小儿肺炎
小儿肺炎是小儿最常见的一种呼吸系统疾病,是由不同病原体或其他因素所致的肺部炎症。小儿肺炎是小儿最常见的一种呼吸系统疾病,是由不同病原体或其他因素所致的肺部炎症。(2)、少去公共场所活动婴幼儿应尽可能避免接触呼吸道感染的病人。有呼吸道感染时尽量不出门,流行季节少串门,不到人流集中的公共场所活动。(3)、加强锻炼,增强体质预防呼吸道感染,注意加强锻炼,可根据年龄选择适当的锻炼方法。小儿肺炎临床表现为发热、咳嗽、气促、呼吸困难和肺部有水泡音,也有不发热而咳喘重者。
0评论2025-11-2035

- 生命中心董晨研究组发现肿瘤免疫治疗新靶点
0评论2025-11-20

- 童馨园试管机构科普:胚胎植入前遗传学检测(PGT)的五大优势
0评论2025-11-19

- 罕见病家庭供卵指南,如何快速匹配基因型卵源?
0评论2025-11-19
- 北京协和绿通隐藏福利:国际患者通道优先匹配
0评论2025-11-19

- 三代试管适合哪些人?宝芝堂生殖专家列出8类最适合人群清单
0评论2025-11-19

- 如何辨别正规试管供卵包男孩机构?5大虚假宣传套路曝光
0评论2025-11-19